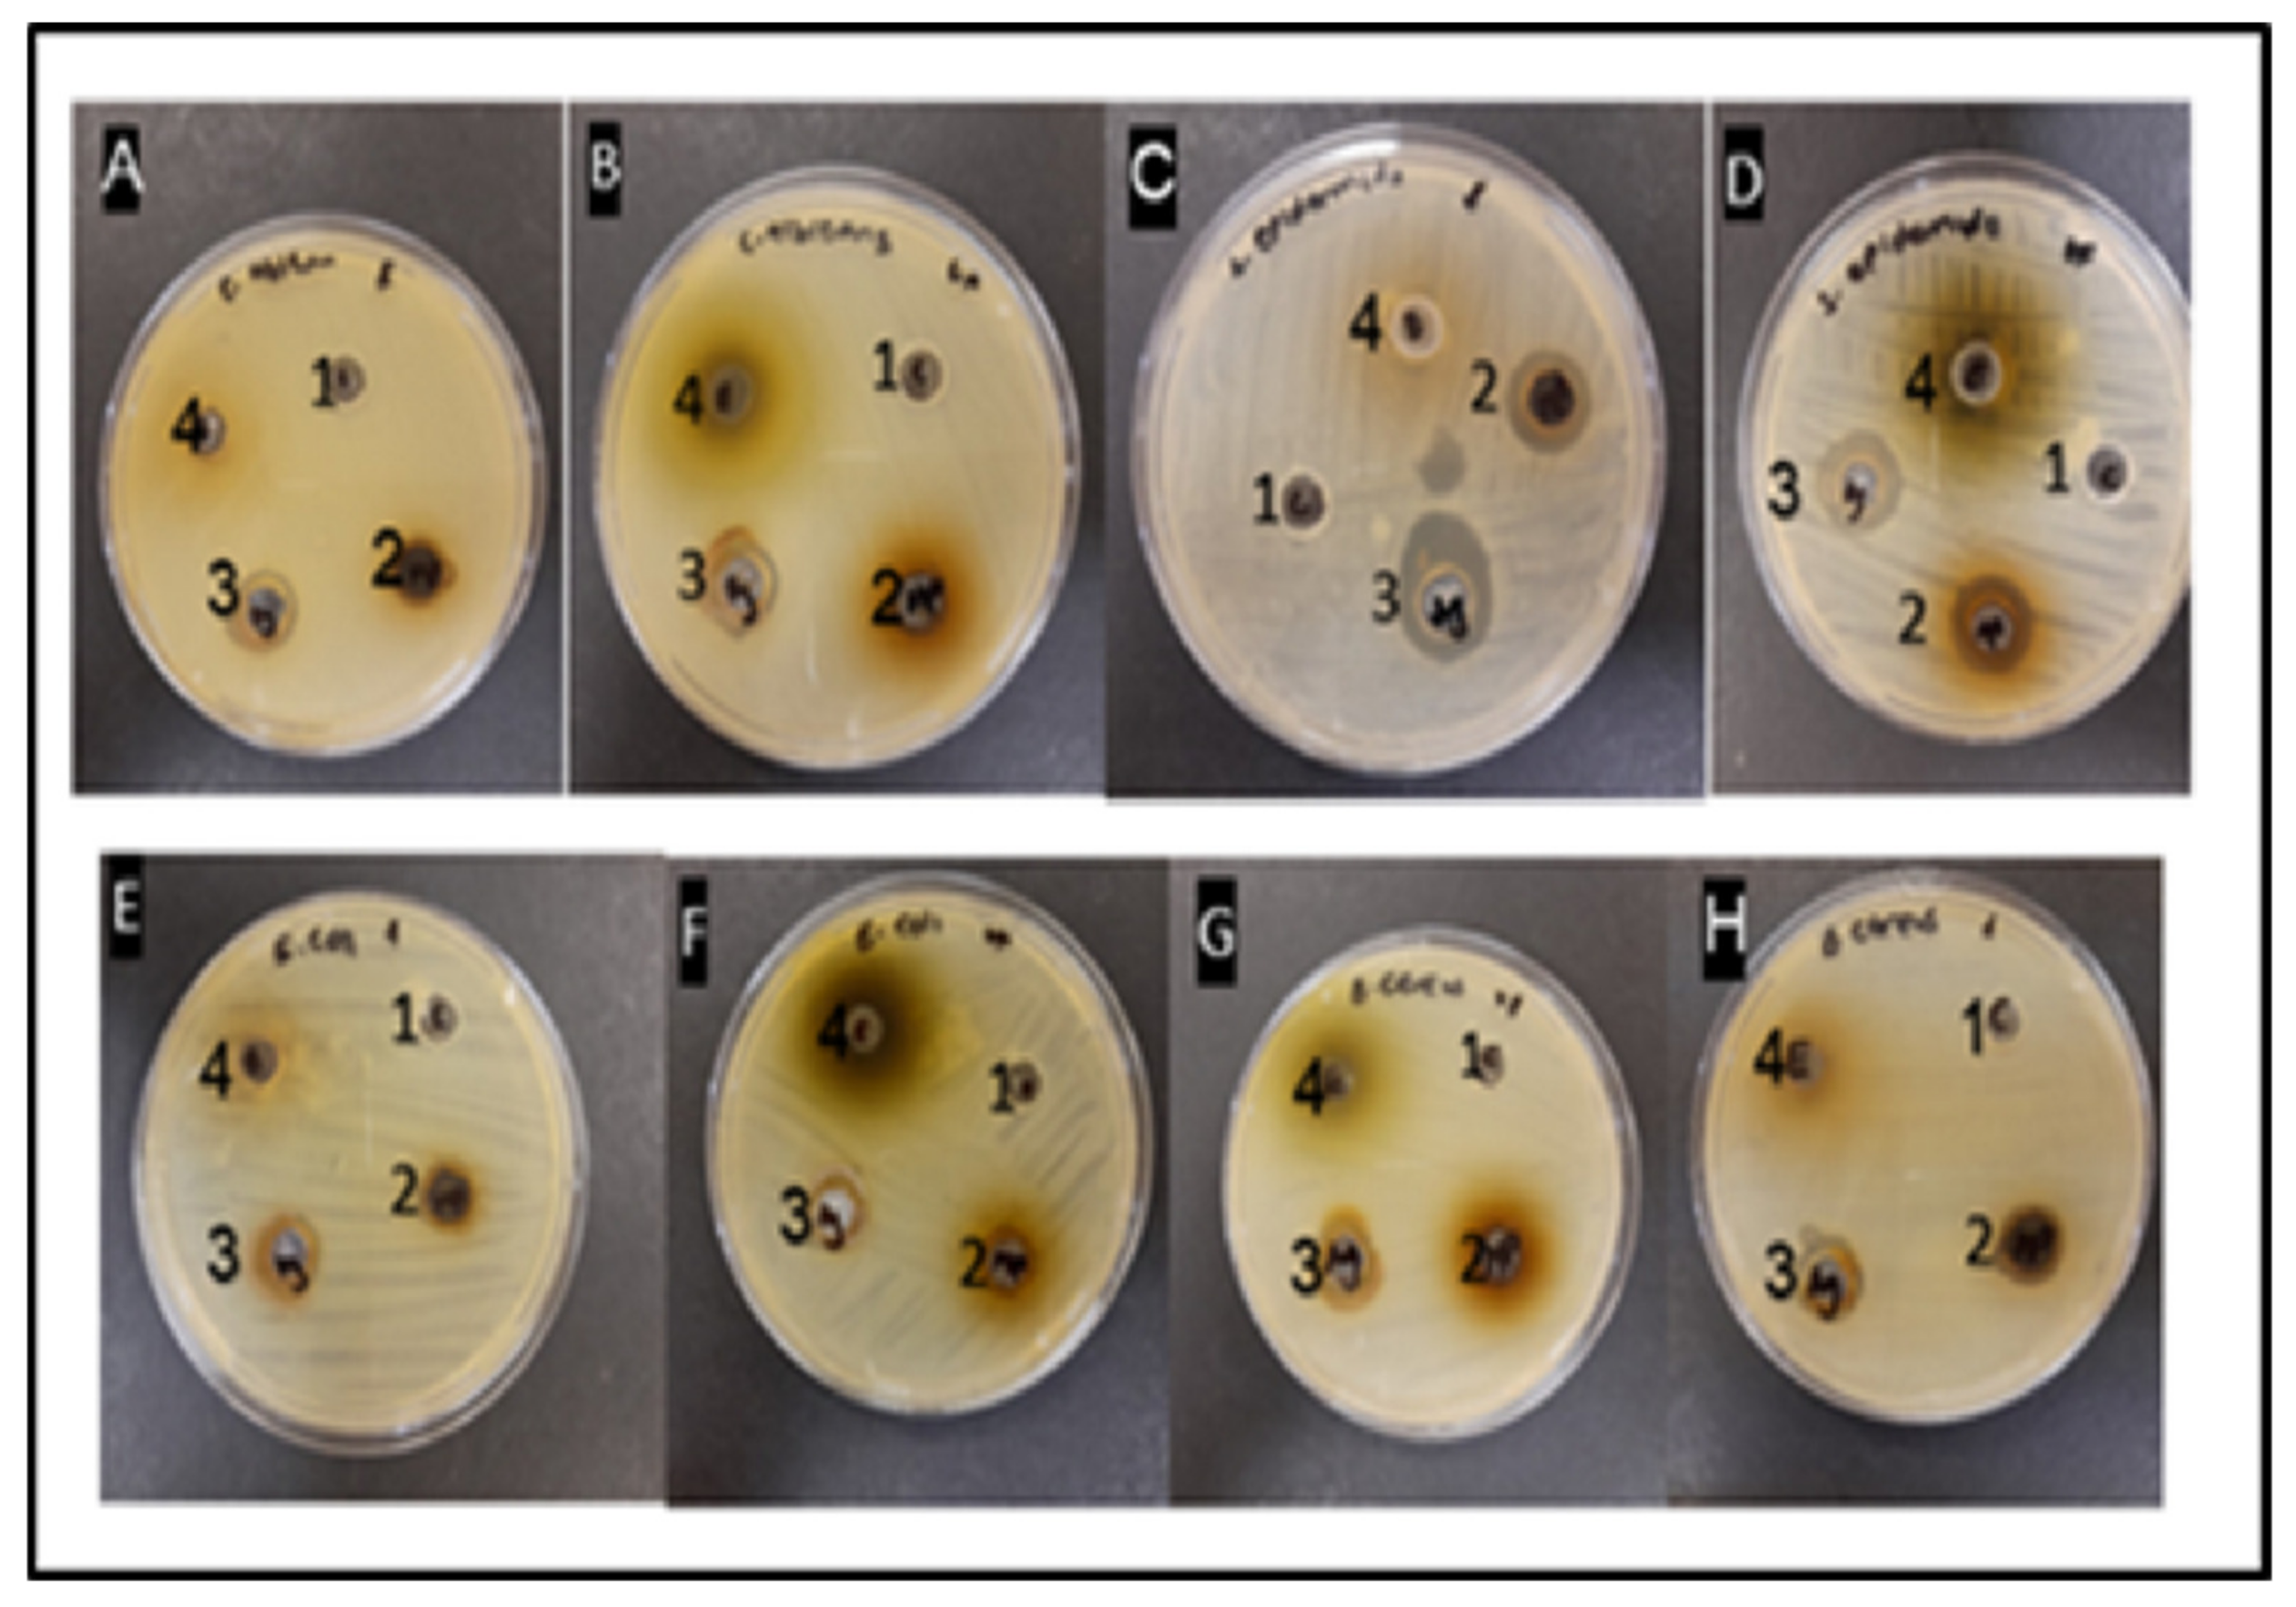
Fermentation 09 00648 g006 Fermentation 09 00648 g006

Biosynthesis of Silver Nanoparticles from Fermented Bush Tea (Athrixia phylicoides DC) Leaf Extract and Evaluation of Their Antioxidant and Antimicrobial Properties
Abstract
1. Introduction
2. Materials and Methods
2.1. Plant Materials and Chemicals
2.2. Preparation of Bush Tea Leave Extract
2.3. Green Synthesis of Silver Nanoparticles
2.4. Characterization of Green Synthesized Silver Nanoparticles
2.5. Antioxidant Properties of Green Synthesized Silver Nanoparticles
2.5.1. Determination of the Total Phenolic Content
2.5.2. Determination of Total Flavonoid Content
2.5.3. DPPH Radical Scavenging Assay
2.5.4. Ferric Reducing Power Assay
2.6. Antimicrobial Activity of Green Synthesized Silver Nanoparticles
2.6.1. Agar Well Diffusion Method
2.6.2. Disk Diffusion Method
2.6.3. Minimum Inhibitory Concentration (MIC)
2.6.4. Minimum Bactericidal Concentration (MBC)
2.7. Statistical Analysis
3. Results and Discussion
3.1. Visual Observation and UV-Visible Spectroscopy of the Green Synthesized Silver Nanoparticles
3.2. FTIR Analysis of Green Synthesized Silver Nanoparticles
3.3. Differential Scanning Calorimetry of Green Synthesized Silver Nanoparticles
3.4. Antioxidant Properties of Green Synthesized Silver Nanoparticles
3.5. Antimicrobial Activity by the Agar Diffusion Method
3.6. Antimicrobial Activity by the Kirby–Bauer Disc Diffusion Method
3.7. Minimum Inhibitory Concentration and Minimum Bactericidal Concentration of Green Synthesized Silver Nanoparticles
4. Conclusions
Author Contributions
Funding
Institutional Review Board Statement
Informed Consent Statement
Data Availability Statement
Conflicts of Interest
References
- Arumugam, S.; Jeyaraman, J.; Pappu, S. Green synthesis of silver nanoparticles using Lippia nodiflora aerial extract and evaluation of their antioxidant, anti-bacterial and cytotoxic effects. Res.-Effic. Technol. 2017, 3, 506–515. [Google Scholar]
- Loo, Y.Y.; Buong, W.C.; Mitsuaki, N.; Son, R. Synthesis of silver nanoparticles by using tea leaf extract from Camellia sinensis. Int. J. Nanomed 2012, 7, 4263–4267. [Google Scholar]
- Saba, F.; Abudul, M.O.; Nazoora, K.; Mohd, S.U. Fabrication of microbicidal silver nanoparticles: Green synthesis and implications in the containment of bacterial biofilm on orthodontal appliances. Front. Nanotechnol 2022, 4, 780783. [Google Scholar]
- Mohammed, R.S.; Mujeeb, K.; Mufsir, K.; Abdulrahman, A.; Hamad, Z.A.; Mohammed, R.H.S.; Jilani, P.; Shaik, A.A.; Adeem, M.; Merajuddin, K.; et al. Plant-extract-assisted green synthesis of silver nanoparticles using Origanum vulgare L. extract and their microbicidal activities. Sustainability 2018, 10, 913. [Google Scholar]
- Fouda, A.; Awad, M.A.; AL-Faifi, Z.E.; Gad, M.E.; Al-Khalaf, A.A.; Yahya, R.; Hamza, M.F. Aspergillus flavus-mediated green synthesis of silver nanoparticles and evaluation of their anti-bacterial, anticandida, acaricides, and photocatalytic activities. Catalysts 2022, 12, 462. [Google Scholar] [CrossRef]
- Huston, M.; DeBella, M.; DiBella, M.; Gupta, A. Green synthesis of nanomaterials. Nanomaterials 2021, 11, 2130. [Google Scholar] [CrossRef]
- Badawy, A.A.; Abdelfattah, N.A.H.; Salem, S.S.; Awad, M.F.; Fouda, A. Efficacy assessment of biosynthesized copper oxide nanoparticles (CuO-NP) in stored grain insects and their impacts on morphological and physiological traits of wheat (Triticum aestivum L.). Plant. Biol. 2021, 10, 233. [Google Scholar] [CrossRef]
- Aritonang, H.F.; Koleangan, H.; Wuntu, A.D. Synthesis of silver nanoparticles using aqueous extract of medicinal plants’ (Impatiens balsamina and Lantana camara) fresh leaves and analysis of antimicrobial activity. Int. J. Microbiol. 2019, 2019, 8642303. [Google Scholar] [CrossRef]
- Loo, Y.Y.; Rukayadi, Y.; Nor-Khaizura, M.A.R.; Kuan, C.H.; Chieng, B.W.; Nishibuchi, M.; Radu, S. In vitro antimicrobial activity of green synthesized silver nanoparticles against selected gram-negative foodborne pathogens. Front. Microbiol. 2018, 9, 1555. [Google Scholar] [CrossRef]
- Martínez Espinosa, J.C.; Carrera Cerritos, R.; Ramírez Morales, M.A.; Sánchez Guerrero, K.P.; Silva Contreras, R.A.; Macías, J.H. Characterization of silver nanoparticles obtained by a green route and their evaluation in the bacterium of Pseudomonas aeruginosa. Crystals 2020, 10, 395. [Google Scholar] [CrossRef]
- Yuan, Y.-G.; Peng, Q.-L.; Gurunathan, S. Effects of silver nanoparticles on multiple drug-resistant strains of Staphylococcus aureus and Pseudomonas aeruginosa from mastitis-infected goats: An alternative approach for antimicrobial therapy. Int. J. Mol. Sci. 2017, 18, 569. [Google Scholar] [CrossRef]
- Malongane, F.; McGaw, L.J.; Nyoni, H.; Mudau, F.N. Metabolic profiling of four South African herbal teas using high resolution liquid chromatography-mass spectrometry and nuclear magnetic resonance. Food Chem. 2018, 257, 90–100. [Google Scholar] [CrossRef]
- Kumar, V.; Bano, D.; Mohan, S.; Singh, D.K.; Hassan, S.H. Sunlight induced green synthesis of silver nanoparticles using aqueous leaf extract of Polyalthia longifolia and its antioxidant activity. Mater. Lett. 2016, 181, 371–377. [Google Scholar] [CrossRef]
- Manasa, D.J.; Chandrashekar, K.R.; Madhu Kumar, D.J.; Niranjana, M.; Meghana Navada, K. Mussaenda frondosa L. mediated facile green synthesis of copper oxide nanoparticles–Characterization, photocatalytic and their biological investigations. Arab. J. Chem. 2021, 14, 103184. [Google Scholar] [CrossRef]
- Nagaraja, S.; Govindarajan, K.; Kalyanaraman, R.; Arvindganth, R.; Bose, R.; Bandar, E.A.; Venugopala, N.; Mahesh, A.; Anroop, B.N.; Rajith, K.K.; et al. Synthesis, characterization, and biological activity of silver nanoparticles synthesized from Aristolochia bracteolata lam. Pharmacogn. Mag. 2020, 16, 568–573. [Google Scholar]
- Kiranmai, M. Biological and non-biological synthesis of metallic nanoparticles. Indian J. Pharm. Sci. 2017, 79, 501–512. [Google Scholar]
- Saleh, G.M.; Najim, S.S. Anti-bacterial activity of silver nanoparticles synthesized from plant latex. Iraqi J. Sci. 2020, 61, 1579–1588. [Google Scholar] [CrossRef]
- Muhammad, R.; Iqra, S.; Shahid, M.R.; Bilal, T.M. A review on green synthesis of silver nanoparticles and their applications. Artif. Cells. Nanomed. Biotechnol. 2016, 45, 1272–1291. [Google Scholar]
- Karthik, N.; Ponnusamy, P.; Balasubramanian, M.G.; Mani, S.; Shivasji, K. Biosynthesis of silver nanoparticles from Streptomyces Spp., characterization and evaluating of its efficacy against Phomopsis theae and Poria hypolateria in tea plants (Camellia sinensis). Nano Biomed. Eng. 2020, 12, 272–280. [Google Scholar]
- Bello, B.A.; Khan, S.A.; Khan, J.A.; Syed, F.Q.; Mirza, M.B.; Shah, L.; Khan, S.B. Anticancer, anti-bacterial, and pollutant degradation potential of silver nanoparticles from Hyphaene thebaica. Biochem. Biophys. Res. Commun. 2017, 490, 889–894. [Google Scholar] [CrossRef]
- Ontong, J.C.; Paosen, S.; Shankar, S.; Voravuthikunchai, S.P. Eco-friendly synthesis of silver nanoparticles using Senna alata bark extract and its antimicrobial mechanism through enhancement of bacterial membrane degradation. J. Microbiol. Methods 2019, 165, 105692. [Google Scholar] [CrossRef] [PubMed]
- Raj, S.; Mali, S.C.; Trivedi, R. Green synthesis and characterization of silver nanoparticles using Enicostemma axillare (Lam.) leaf extract. Biochem. Biophys. Res. Commun. 2018, 503, 2814–2819. [Google Scholar] [CrossRef] [PubMed]
- Gopinath, V.; MubarakAli, D.; Priyadarshini, S.; Priyadharsshini, N.M.; Thajuddin, N.; Velusamy, P. Biosynthesis of silver nanoparticles from Tribulus terrestris and its antimicrobial activity: A novel biological approach. Colloids Surf. B Biointerfaces 2012, 96, 69–74. [Google Scholar] [CrossRef] [PubMed]
- Royhan Uddin, A.K.M.; Bakar Siddique, M.A.; Rahman, F.; Atique Ullah, A.K.M.; Khan, K. Cocos nucifera leaf extract mediated green synthesis of silver nanoparticles for enhanced anti-bacterial activity. J. Inorg. Organomet Polym. Mater. 2020, 30, 3305–3316. [Google Scholar] [CrossRef]
- Hlahla, L.N.; Mudau, F.N.; Mariga, I.K. Effect of fermentation temperature and time on the chemical composition of bush tea (Athrixia phylicoides DC.). J. Med. Plant Res. 2010, 4, 824–829. [Google Scholar]
- Mathivha, L.P.; Mudau, N.F. Response of total phenolic content and antioxidant activities of bush tea and special tea using different selected extraction solvents. J. Consum. Sci. 2017, 45, 27–33. [Google Scholar]
- Lerotholi, L.; Chaudhary, S.K.; Combrinck, S.; Viljoen, A. Bush tea (Athrixia phylicoides): A review of traditional uses, bioactivity, and phytochemical. South Afr. J. Bot. 2017, 110, 4–17. [Google Scholar] [CrossRef]
- Maedza, K.V.; Mpumelelo, N.; Wonde, N.; Nokwanda, P.M.; Mudau, F.N. Response of phytochemicals in bush tea (Athrixia phylicoides DC.) as influenced by selected micronutrients. HortScience 2017, 52, 965–971. [Google Scholar]
- Ramphinwa, M.L.; Mchau, G.R.A.; Madala, N.E.; Nengovhela, N.; John, B.O.; Ogola, J.B.O.; Mudau, F.N. Response of plant growth and development, and accumulation of hydroxyl-cinnamoyl acid derivatives to selected shade nets and seasonality of field-grown bush tea (Athrixia phylicoides DC.). HortScience 2022, 57, 87–96. [Google Scholar] [CrossRef]
- Kaningini, G.A.; Azizi, S.; Nyoni, H.; Mudau, F.N.; Mohale, K.C.; Maaza, M. Green synthesis and characterization of zinc oxide nanoparticles using bush tea (Athrixia phylicoides DC) natural extract: Assessment of the synthesis process. F1000Research 2022, 10, 1077. [Google Scholar] [CrossRef]
- Ayinde, W.B.; Gitari, M.W.; Muchindu, M.; Samie, A. Biosynthesis of ultrasonically modified Ag-MgO nanocomposite and its potential for antimicrobial activity. J. Nanotechnol. 2018, 56, 5–16. [Google Scholar] [CrossRef]
- Wang, D.; Xue, B.; Wang, L.; Zhang, Y.; Liu, L.; Zhou, Y. Fungus-mediated green synthesis of nano-silver using Aspergillus sydowii and its anti-fungal/antiproliferative activities. Sci. Rep. 2021, 11, 10356. [Google Scholar] [CrossRef]
- Yadav, S.; Patil, S.H.; Patel, P.; Nair, V.; Khan, S.; Kakkar, S.; Durve, A. Green synthesis of silver nanoparticles from plant sources and evaluation of their antimicrobial activity. Adv. Anal. Tools Mat. Charact. 2018, 5, 133–139. [Google Scholar]
- Akintola, A.O.; Kehinde, B.D.; Ayoola, P.B.; Adewoyin, A.G.; Adedose, O.T.; Ajayi, J.F.; Ogunsona, S.B. Antioxidant properties of silver nanoparticles biosynthesized from methanolic leaf extract of Blighia sapida. IOP Conf. Ser. Mater. Sci. Eng. 2017, 805, 012004. [Google Scholar] [CrossRef]
- Souza, B.W.S.; Vincente, A.A. Chemical characterization and antioxidant activity of sulfated polysaccharide from the seaweed Gracilaria birdiae. Food Hydrocoll. 2012, 27, 287–292. [Google Scholar] [CrossRef]
- Lin, S.; Cheng, Y.; Liu, J.; Wiesner, M.R. Polymeric coatings on silver nanoparticles hinder autoaggregation but enhance attachment to uncoated surfaces. Langmuir 2012, 28, 4178–4186. [Google Scholar] [CrossRef]
- CLSI. Performance Standards for Antimicrobial Susceptibility Testing; Twenty-Second Informational Supplement; The Clinical and Laboratory Standards Institute: Wayne, PA, USA, 2012. [Google Scholar]
- Mukaratirwa-Muchanyereyi, N.; Muchenje, T.; Nyoni, S.; Shumba, M.; Mupa, M.; Luke Gwatidzo, L.; Rahman, A. Green synthesis of silver nanoparticles using Euphorbia confinalis stem extract, characterization and evaluation of antimicrobial activity. J. Nanomater. Mol. Nanotechnol. 2017, 6, 3. [Google Scholar]
- Melkamu, W.; Bitew, L.G. Green synthesis of silver nanoparticles using Hagenia abyssinica (Bruce) J.F. Gmel plant leaf extract and their anti-bacterial and antioxidant activities. Heliyon 2021, 7, e08459. [Google Scholar] [CrossRef]
- Ibrahim, H.M.M. Green synthesis and characterization of silver nanoparticles using banana peel extract and their antimicrobial activity against representative microorganisms. Radiat. Res. Appl. Sci. 2015, 8, 265–476. [Google Scholar] [CrossRef]
- Hoda, E.; Hamid, R.; Saeed, N. Synthesis and characterization of novel silver nanoparticles using Chamaemelum nobile extract for anti-bacterial application. Adv. Nat. Sci: NanoSci. Nanotechnol. 2017, 8, 025004. [Google Scholar]
- Abbas, S.D. Biosynthesis of silver nanoparticles using lactobacillus and their effects on oxidative stress biomarkers in rats. J. King Saud Univ. Sci. 2017, 29, 462–467. [Google Scholar]
- Prathibha, B.S.; Shanmuga Priya, K. Green synthesis of silver nanoparticles using Tabebuia aurea leaf extract. IOSR J. Appl. Chem. 2017, 10, 23–29. [Google Scholar] [CrossRef]
- Elemike, E.E.; Onwudiwe, D.C.; Arijeh, O.; Nwankwo, H.U. Plant-mediated biosynthesis of silver nanoparticles by leaf extracts of Lasienthra africanum and a study of the influence of kinetic parameters. Bull. Mater. Sci. 2017, 40, 129–137. [Google Scholar] [CrossRef]
- Somayeh, F.; Mina, J.; Mohammad, Y. Biologically synthesized silver nanoparticles by aqueous extract of Satureja intermedia C.A. Mey and the evaluation of total phenolic and flavonoid contents and antioxidant activity. J. Nanostructure Chem. 2016, 6, 357–364. [Google Scholar]
- Gomathia, M.; Prakasama, A.; Rajkumarb, P.V.; Rajeshkumarc, S.; Chandrasekarand, R.; Anbarasan, P.M. Green synthesis of silver nanoparticles using Gymnema sylvestre leaf extract and evaluation of its anti-bacterial activity. South Afr. J. Chem. Eng. 2020, 32, 1–4. [Google Scholar] [CrossRef]
- Wang, W.; Yu, Z.; Alsammarraie, F.K.; Kong, F.; Lin, M.; Mustapha, A. Properties and antimicrobial activity of polyvinyl alcohol-modified bacterial nanocellulose packaging films incorporated with silver nanoparticles. Food Hydrocoll. 2021, 100, 105411. [Google Scholar] [CrossRef]
- Akinnuoye, A.G.; Salawu, Q.O.; James, O.G. Characterization of biosynthesized silver nanoparticles using UV-visible and FTIR Spectroscopy. Afr. J. Environ. Sci. Technol. 2020, 3, 21–26. [Google Scholar]
- Huang, J.; Li, Q.; Sun, D.; Lu, Y.; SU, Y.; Yang, X.; Wang, H.; Wang, Y.; Shao, W.; He, N.; et al. Biosynthesis of silver and gold nanoparticles by novel sundried Cinnamomum camphora leaf. Nanotechnology 2007, 18, 105104. [Google Scholar] [CrossRef]
- Sharifi-Rad, M.; Pohl, P.; Epifano, F.; Álvarez-Suarez, J.M. Green synthesis of silver nanoparticles using Astragalus tribuloides Delile. root extract: Characterization, antioxidant, anti-bacterial, and anti-inflammatory activities. Nanomaterials 2020, 10, 2383. [Google Scholar] [CrossRef]
- Tahir, R.; Muhammad, B.; Iqbal, H.M.N.; Li, C. Green biosynthesis of silver nanoparticles using leaves extract of Artemisia vulgaris and their potential biomedical applications. Colloids Surf. B Biointerfaces 2017, 158, 408–415. [Google Scholar]
- Vasudeo, K.; Priya, T. Biosynthesis of silver nanoparticles by using the Cinnamon (Dalchini) extract. Curr. Pharma Res. 2019, 9, 2716–2720. [Google Scholar]
- Rajeswari, A.; Sujatha, D.; Balasaraswathi, K.; Mani, U.; Chellan, R.; Asit, B.M. Phytosynthesis of silver nanoparticles using Coccinia grandis leaf extract and its application in the photocatalytic degradation. Colloids Surf. B Biointerfaces 2012, 94, 226–230. [Google Scholar]
- Rohan, S.P.; Anup, S.H. Sunlight induced green synthesis of silver nanoparticles using sundried leaves extract of Kalanchoe pinnata and evaluation of its photocatalytic potential. Pharm. Lett. 2015, 7, 313–324. [Google Scholar]
- Mohanta, Y.K.; Panda, S.K.; Biswas, K.; Tamang, A.; Bandyopadhyay, J.; De, D.; Mohanta, D.; Bastia, A.K. Biogenic synthesis of silver nanoparticles from Cassia fistula (Linn.): In vitro assessment of their antioxidant, antimicrobial and cytotoxic activities. IET Nanobiotechnol. 2016, 10, 438–444. [Google Scholar] [CrossRef]
- Abdel-Aziz, M.S.; Shaheen, M.S.; El-Nekeety, A.A.; Abdel-Wahhab, M.A. Antioxidant and anti-bacterial activity of silver nanoparticles biosynthesized using Chenopodium murale leaf extract. J. Saudi Chem. Soc. 2014, 18, 356–363. [Google Scholar] [CrossRef]
- Fafal, T.; Taştan, P.; Tüzün, B.S.; Ozyazici, M.; Kivcak, B. Synthesis, characterization and studies on antioxidant activity of silver nanoparticles using Asphodelus aestivus Brot. aerial part extract. S. Afr. J. Bot. 2017, 112, 346–353. [Google Scholar] [CrossRef]
- Dhanapal, A.C.T.A.; Warrant, A.N. Impact of Ocimum tenuiflorum mediated green synthesis of silver nanoparticles on in-vitro antioxidant and anti-bacterial activities. Int. J. Pharm. Qual. Assur. 2020, 11, 379–388. [Google Scholar] [CrossRef]
- Nazarni, R.; Purnama, D.; Umar, S.; Eni, H. The effect of fermentation on total phenolic, flavonoid, and tannin content and its relation to anti-bacterial activity in Jaruk tigarun (Crataeva nurvala, Buch HAM). Int. Food Res. J. 2016, 23, 309–315. [Google Scholar]
- Vorobyova, V.; Vasyliev, G.; Skiba, M. Eco friendly green synthesis of silver nanoparticles with the black currant pomace extract and its anti-bacterial, electrochemical, and antioxidant activity. Appl. NanoSci. 2020, 10, 4523–4534. [Google Scholar] [CrossRef]
- Hussain, P.R.; Rather, S.A.; Suradkar, P.P. Structural characterization and evaluation of antioxidant, anticancer and hypoglycemic activity of radiation degraded oat (Avena sativa) β- glucan. Radiat. Phys. Chem. 2018, 144, 218–230. [Google Scholar] [CrossRef]
- De Marco Castro, E.; Shannon, E.; Abu-Ghannam, N. Effect of fermentation on enhancing the nutraceutical properties of Arthrospira platensis (Spirulina). Fermentation 2019, 5, 28. [Google Scholar] [CrossRef]
- Rabeta, M.S.; Lai, S.Y. Effects of drying, fermented and unfermented tea of Ocimum tenuiflorum Linn. on the antioxidant capacity. Int. Food Res. J. 2013, 20, 1601–1608. [Google Scholar]
- Zangeneh, M.M.; Saneei, S.; Zangeneh, A. Preparation, characterization, and evaluation of cytotoxicity, antioxidant, cutaneous wound healing, anti-bacterial, and anti-fungal effects of gold nanoparticles using the aqueous extract of Falcaria vulgaris leaves. Appl. Organomet. Chem. 2019, 33, 5263. [Google Scholar] [CrossRef]
- Netai, M.M.; Stephen, N.; Musekiwa, C. Synthesis of silver nanoparticles using wild Cucumis anguria: Characterization and anti-bacterial activity. Afr. J. Biotechnol. 2017, 16, 1911–1921. [Google Scholar]
- Vidal, J.; Huiliñir, C.; Santander, R.; Silva-Agredo, J.; Torres-Palma, R.A.; Salazar, R. Degradation of ampicillin antibiotic by electrochemical processes: Evaluation of antimicrobial activity of treated water. Environ. Sci. Pollut. Res. 2019, 26, 4404–4414. [Google Scholar] [CrossRef] [PubMed]
- Roy, A.; Bulut, O.; Some, S.; Mandal, A.K.; Yilmaz, M.D. Green synthesis of silver nanoparticles: Biomolecule-nanoparticle organisations targeting antimicrobial activity. RSC Adv. 2019, 9, 2673–2702. [Google Scholar] [CrossRef]
- Siddiqui, M.N.; Redhwi, H.H.; Achilias, D.S.; Kosmidou, E.; Vakalopoulou, E.; Ioannidou, M.D. Green synthesis of silver nanoparticles and study of their antimicrobial properties. J. Polym. Environ. 2018, 26, 423–433. [Google Scholar] [CrossRef]
- Ahmed, S.; Ahmad, M.; Swami, B.L.; Ikram, S. A review on plants extract mediated synthesis of silver nanoparticles for antimicrobial applications: A green expertise. J. Adv. Res. 2016, 7, 17–28. [Google Scholar] [CrossRef]
- Salman, H.D. Evaluation and comparison the anti-bacterial activity of silver nano particles (AgNPs) and silver nitrate (AgNO3) on some pathogenic bacteria. J. Glob. Pharma Technol. 2017, 9, 238–248. [Google Scholar]
- Ocsy, I.; Demirbas, A.; McLamore, E.; Altinsoy, B.; Ildiz, N.; Baldemir, A. Green synthesis incorporated hydrothermal approaches for silver nanoparticles formation and enhanced antimicrobial activity against bacterial and fungal pathogens. J. Mol. Liq. 2017, 238, 263–269. [Google Scholar] [CrossRef]

| Sample | To (°C) | Tp (°C) | Tc (°C) | Delta H |
|---|---|---|---|---|
| Fermented AgNPs | 62.45 ± 14.16 b | 48.48 ± 12.88 a | 79.27 ± 14.67 a | 4.39 ± 5.15 a |
| Unfermented AgNPs | 48.01 ± 4.17 a | 39.18 ± 8.30 b | 59.26 ± 17.01 b | 11.98 ± 8.26 b |
Microorganisms | Zone of Inhibition (mm *) | ||
|---|---|---|---|
| Unfermented AgNPs | Fermented AgNPs | AgNO3 | |
| B. cereus | 10.73 0.18 a | 13.28 0.25 a | 11.87 1.17 a |
| S. epidermidis | 15.88 0.34 b | 14.33 2.69 b | 13.55 2.14 b |
| E. coli | 10.45 0.39 a | 12.03 0.69 a | 11.27 0.41 a |
| C. albicans | 10.79 0.18 a | 12.09 0.38 a | 12.45 0.55 a |
Microorganisms | Zone of Inhibition (mm *) | |||
|---|---|---|---|---|
| Unfermented AgNPs | Fermented AgNPs | AgNO3 | Ampicillin | |
| B. cereus | 8.60 | 8.97 | 8.60 | 0 |
| S. epidermidis | 9.41 | 10.16 | 7.82 | 7.00 |
| E. coli | 8.74 | 9.17 | 8.17 | 9.05 |
| C. albicans | 7.71 | 9.06 | 8.57 | 6.93 |
Microorganisms | Unfermented AgNPs | Fermented AgNPs | ||
|---|---|---|---|---|
| MIC (µg/mL) | MBC (µg/mL) | MIC (µg/mL) | MBC (µg/mL) | |
| B. cereus | 72.91 47.69 b | 125 0.00 c | 52.08 18.4 b | 62.5 0.00 b |
| S. epidermidis | 62.5 0.00 a | 62.5 0.00 a | 4.85 1.15 a | 7.9 0.00 a |
| E. coli | 62.5 0.00 a | 62.5 0.00 a | 41.66 18.04 b | 62.5 0.00 b |
| C. albicans | 72.91 47.7 b | 72.91 0.00 b | 83.33 36.15 c | 125 0.00 c |
Disclaimer/Publisher’s Note: The statements, opinions and data contained in all publications are solely those of the individual author(s) and contributor(s) and not of MDPI and/or the editor(s). MDPI and/or the editor(s) disclaim responsibility for any injury to people or property resulting from any ideas, methods, instructions or products referred to in the content. |
© 2023 by the authors. Licensee MDPI, Basel, Switzerland. This article is an open access article distributed under the terms and conditions of the Creative Commons Attribution (CC BY) license (https://creativecommons.org/licenses/by/4.0/).
Share and Cite
Mashau, M.E.; Mamagau, T.; Foforane, K.; Nethathe, B.; Ramphinwa, M.L.; Mudau, F.N. Biosynthesis of Silver Nanoparticles from Fermented Bush Tea (Athrixia phylicoides DC) Leaf Extract and Evaluation of Their Antioxidant and Antimicrobial Properties. Fermentation 2023, 9, 648. https://doi.org/10.3390/fermentation9070648
Mashau ME, Mamagau T, Foforane K, Nethathe B, Ramphinwa ML, Mudau FN. Biosynthesis of Silver Nanoparticles from Fermented Bush Tea (Athrixia phylicoides DC) Leaf Extract and Evaluation of Their Antioxidant and Antimicrobial Properties. Fermentation. 2023; 9(7):648. https://doi.org/10.3390/fermentation9070648
Chicago/Turabian StyleMashau, Mpho Edward, Theshano Mamagau, Kgethego Foforane, Bono Nethathe, Maanea Lonia Ramphinwa, and Fhatuwani Nixwell Mudau. 2023. "Biosynthesis of Silver Nanoparticles from Fermented Bush Tea (Athrixia phylicoides DC) Leaf Extract and Evaluation of Their Antioxidant and Antimicrobial Properties" Fermentation 9, no. 7: 648. https://doi.org/10.3390/fermentation9070648
APA StyleMashau, M. E., Mamagau, T., Foforane, K., Nethathe, B., Ramphinwa, M. L., & Mudau, F. N. (2023). Biosynthesis of Silver Nanoparticles from Fermented Bush Tea (Athrixia phylicoides DC) Leaf Extract and Evaluation of Their Antioxidant and Antimicrobial Properties. Fermentation, 9(7), 648. https://doi.org/10.3390/fermentation9070648






